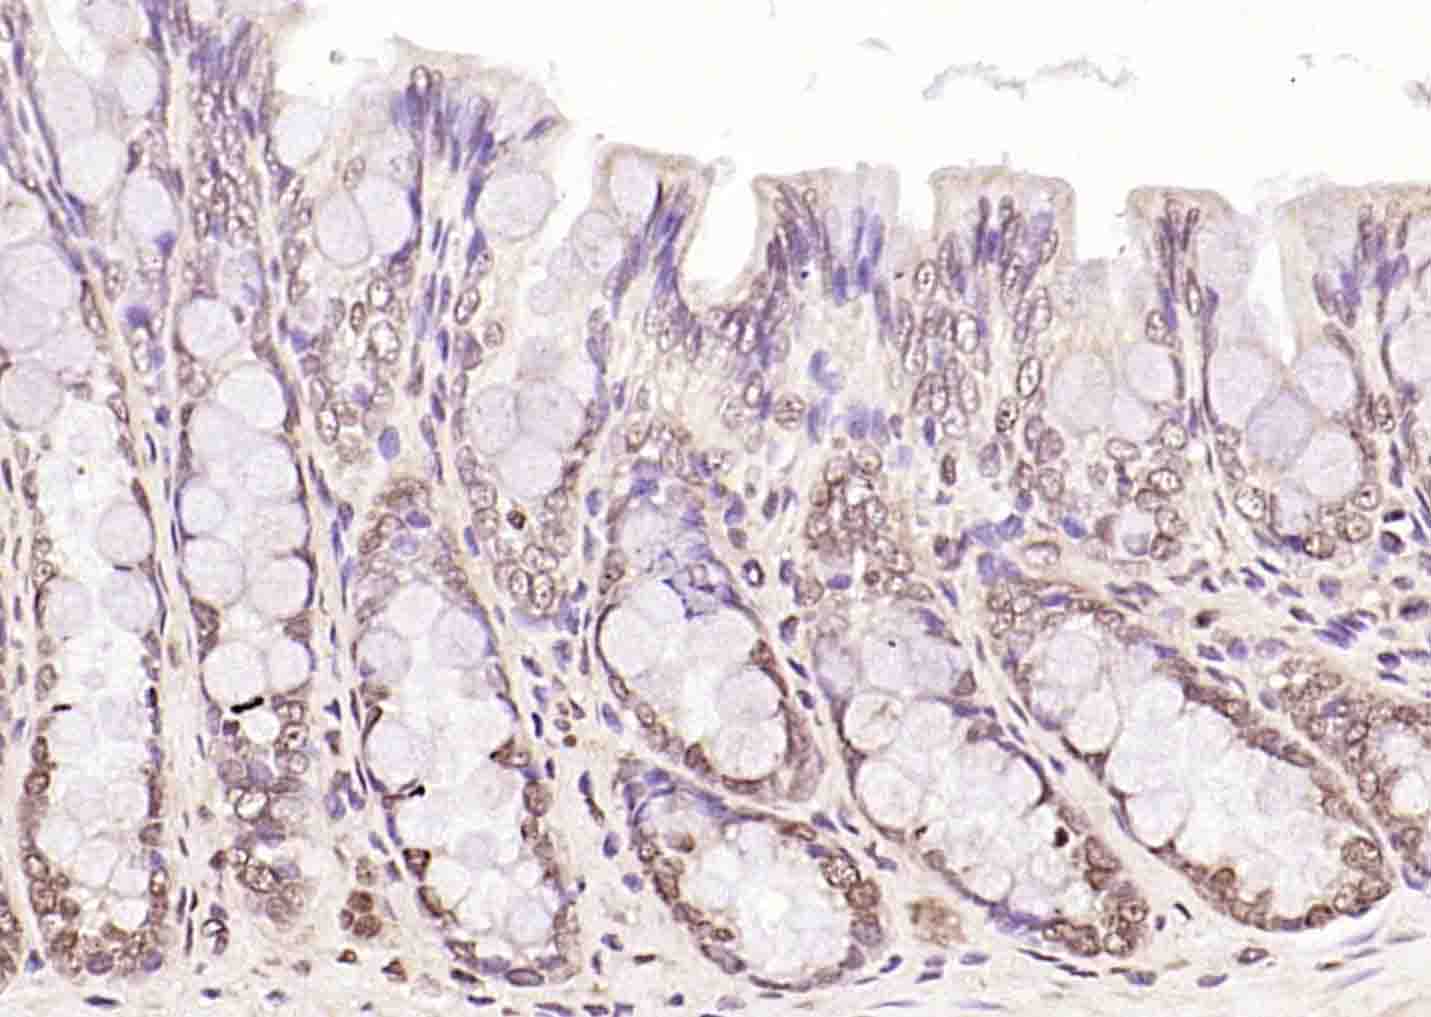
磷酸化丝氨酸/苏氨酸蛋白激酶抗体-bs-3249R

phospho-LKB1 (Ser428) Rabbit pAb (一抗) | Bioss

货号:bs-3249R
产品详情
相关标记
相关产品
相关文献
常见问题
概述
产品编号
bs-3249R
产品类型
磷酸化抗体、p53 pathway、宠物抗体、农牧业/家禽抗体
英文名称
phospho-LKB1 (Ser428) Rabbit pAb
中文名称
磷酸化丝氨酸/苏氨酸蛋白激酶抗体
英文别名
STK11 | LKB1 (phospho-S428); p-LKB1; phospho-LKB1; p-STK11; STK11 | LKB1 (phospho-Ser428); LKB1; PJS; hLKB1; Par-4; STK11_HUMAN; STK11; Liver kinase B1 (LKB1 | hLKB1); Renal carcinoma antigen NY-REN-19; 2.7.11.1; STK11_MOUSE; Liver kinase B1 homolog (LKB1 | mLKB1);
抗体来源
Rabbit
免疫原
KLH conjugated Synthesised phosphopeptide derived from human LKB1 around the phosphorylation site of Ser428: RL(p-S)AC
亚型
IgG
性状
Liquid
纯化方法
affinity purified by Protein A
克隆类型
Polyclonal
理论分子量
48 kDa
检测分子量
48 kDa
浓度
1mg/ml
储存液
0.01M TBS (pH7.4) with 1% BSA, 0.02% Proclin300 and 50% Glycerol.
研究领域
Cancer > Cancer Metabolism > Metabolic signaling pathway > Integration of energy metabolism
Cancer > Cell cycle > Cell cycle inhibitors > p53 pathway
Cancer > Oncoproteins/suppressors > Tumor suppressors > p53 pathway
Cell Biology > Cell Cycle > Cell Cycle Inhibitors > p53
Metabolism > Pathways and Processes > Metabolic signaling pathways > Energy transfer pathways > Integration of energy
SWISS
Gene ID
保存条件
Shipped at 4℃. Store at -20℃ for one year. Avoid repeated freeze/thaw cycles.
注意事项
This product as supplied is intended for research use only, not for use in human, therapeutic or diagnostic applications.
数据库链接
产品介绍
LKB1基因是一种抑癌基因,也是一种丝氨酸/苏氨酸蛋白激酶.LKB1的功能主要是使细胞周期阻滞在G1期、促进细胞凋亡和调节胚胎血管形成等.LKB1基因的胚系突变是Peutz-Jeghers综合征的主要致病因素.在散发肿瘤中也发现有LKB1基因突变,其中以肺腺癌和子宫颈粘液癌突变率较高。
背景资料
This gene, which encodes a member of the serine/threonine kinase family, regulates cell polarity and functions as a tumor suppressor. Mutations in this gene have been associated with Peutz-Jeghers syndrome, an autosomal dominant disorder characterized by the growth of polyps in the gastrointestinal tract, pigmented macules on the skin and mouth, and other neoplasms. Alternate transcriptional splice variants of this gene have been observed but have not been thoroughly characterized. [provided by RefSeq, Jul 2008].

产品应用
| 应用 | 已检合格种属 | 预测种属 | 推荐稀释比例 |
|---|---|---|---|
| WB | Human | Mouse, Rat, Cow, Dog, Horse | 1:500-2000 |
| IHC-P | Human, Mouse, Rat | Cow, Dog, Horse | 1:100-500 |
| IHC-F | Human, Mouse, Rat | Cow, Dog, Horse | 1:100-500 |
| IF | Human, Mouse, Rat | Cow, Dog, Horse | 1:100-500 |
| Flow-Cyt | Human | Mouse, Rat, Cow, Dog, Horse | 1ug/Test |
交叉反应
交叉反应: Human, Mouse, Rat (predicted: Cow, Dog, Horse)
相关产品
暂无相关产品
靶标
基因名
STK11
蛋白名
Serine/threonine-protein kinase STK11
亚基
Catalytic component of a trimeric complex composed of STK11/LKB1, STRAD (STRADA or STRADB) and CAB39/MO25 (CAB39/MO25alpha or CAB39L/MO25beta): the complex tethers STK11/LKB1 in the cytoplasm and stimulates its catalytic activity. Found in a ternary complex composed of SMAD4, STK11/LKB1 and STK11IP. Interacts with p53/TP53, SMAD4, STK11IP and WDR6.
亚细胞定位
Nucleus. Cytoplasm. Membrane. Mitochondrion. Note=A small fraction localizes at membranes. Relocates to the cytoplasm when bound to STRAD (STRADA or STRADB) and CAB39/MO25 (CAB39/MO25alpha or CAB39L/MO25beta). Translocates to mitochondrion during apoptosis.
组织特异性
Ubiquitously expressed. Strongest expression in testis and fetal liver.
翻译后修饰
Phosphorylated by ATM at Thr-363 following ionizing radiations (IR). Phosphorylation at Ser-428 by RPS6KA1 and/or some PKA is required to inhibit cell growth. Phosphorylation at Ser-428 is also required during neuronal polarization to mediate phosphorylation of BRSK1 and BRSK2.
疾病
Defects in STK11 are a cause of Peutz-Jeghers syndrome
(PJS) [MIM:175200]. PJS is a rare hereditary disease in which there is predisposition to benign and malignant tumors of many organ systems. PJS is an autosomal dominant disorder characterized by melanocytic macules of the lips, multiple gastrointestinal hamartomatous polyps and an increased risk for various neoplasms, including gastrointestinal cancer.
Defects in STK11 have been associated with testicular tumors (TEST) [MIM:273300]. A common solid malignancy in males. Germ cell tumors of the testis constitute 95% of all testicular neoplasms.
Note=Defects in STK11 are associated with some sporadic cancers, especially lung cancers. Frequently mutated and inactivated in non-small cell lung cancer (NSCLC). Defects promote lung cancerigenesis process, especially lung cancer progression and metastasis. Confers lung adenocarcinoma the ability to trans-differentiate into squamous cell carcinoma. Also able to promotes lung cancer metastasis, via both cancer-cell autonomous and non-cancer-cell autonomous mechanisms.
Defects in STK11 have been associated with testicular tumors (TEST) [MIM:273300]. A common solid malignancy in males. Germ cell tumors of the testis constitute 95% of all testicular neoplasms.
Note=Defects in STK11 are associated with some sporadic cancers, especially lung cancers. Frequently mutated and inactivated in non-small cell lung cancer (NSCLC). Defects promote lung cancerigenesis process, especially lung cancer progression and metastasis. Confers lung adenocarcinoma the ability to trans-differentiate into squamous cell carcinoma. Also able to promotes lung cancer metastasis, via both cancer-cell autonomous and non-cancer-cell autonomous mechanisms.
相似性
Belongs to the protein kinase superfamily. CAMK Ser/Thr protein kinase family. LKB1 subfamily.
Contains 1 protein kinase domain.
Contains 1 protein kinase domain.
功能
Tumor suppressor serine/threonine-protein kinase that controls the activity of AMP-activated protein kinase (AMPK) family members, thereby playing a role in various processes such as cell metabolism, cell polarity, apoptosis and DNA damage response. Acts by phosphorylating the T-loop of AMPK family proteins, leading to promote their activity: phosphorylates PRKAA1, PRKAA2, BRSK1, BRSK2, MARK1, MARK2, MARK3, MARK4, NUAK1, NUAK2, SIK1, SIK2, SIK3 and SNRK but not MELK. Also phosphorylates non-AMPK family proteins such as STRADA and possibly p53/TP53. Acts as a key upstream regulator of AMPK by mediating phosphorylation and activation of AMPK catalytic subunits PRKAA1 and PRKAA2: it thereby regulates inhibition of signaling pathways that promote cell growth and proliferation when energy levels are low, glucose homeostasis in liver, activation of autophagy when cells undergo nutrient deprivation, B-cell differentiation in the germinal center in response to DNA damage. Also acts as a regulator of cellular polarity by remodeling the actin cytoskeleton. Required for cortical neurons polarization by mediating phosphorylation and activation of BRSK1 and BRSK2, leading to axon initiation and specification. Involved in DNA damage response: interacts with p53/TP53 and recruited to the CDKN1A/WAF1 promoter to participate to transcription activation. Able to phosphorylate p53/TP53; the relevance of such result in vivo is however unclear and phosphorylation may be indirect and mediated by downstream STK11/LKB1 kinase NUAK1 Also acts as a mediator p53/TP53-dependent apoptosis via interaction with p53/TP53: translocates to mitochondrion during apoptosis and regulates p53/TP53-dependent apoptosis pathways.
同靶标产品
相关文献
提示: 发表研究结果有使用 bs-3249R 时请让我们知道,以便我们可以引用参考文章。作为回馈,资料提供者将获得我们送上的小礼品。
具体参考文献:bs-3249R 被引用于4文献中